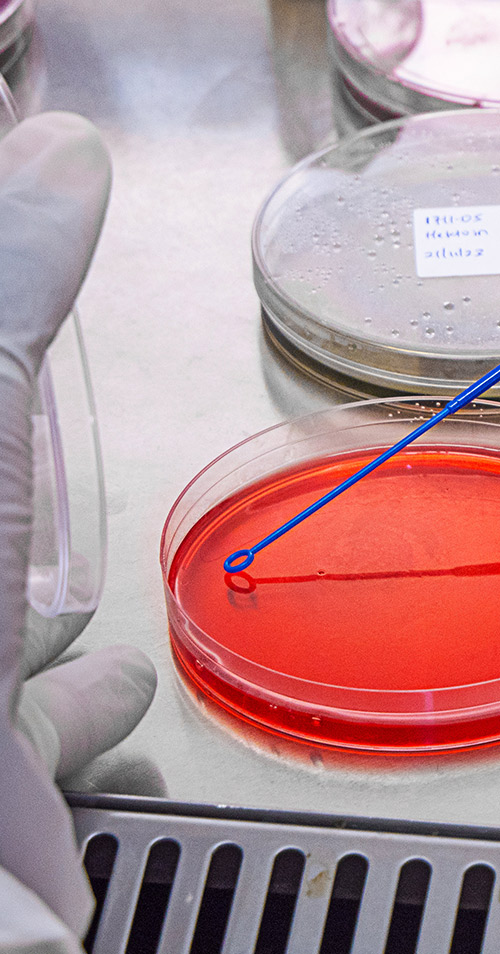
-

+254 723872168 | knancy [at] interfieldlabs.co.ke
IFTL guarantees quality and competitive testing services to food and non-food supply value chain stakeholders such as (farmers, distributors, manufactures, processors, traders, packers and product handlers for storage and display and consumers.
Our scope of testing for quality and nutritional analysis includes;
i) Physical tests such as Grading, Organoleptic/Sensory Evaluation, Cook Test
ii) Chemical tests including;
- Digestion, Titration, and Ashing Wet Chemistry tests for food, oil, seeds, water
- Mycotoxins (Total Aflatoxin, Aflatoxin B1,B2, G1, G2 & M1, Fumonisin, DON, zearalenone, Ochratoxin),
- Screening and quantification of Pesticide Residue, Glyphosate, Pyrroliziine Alkaloids (PA)
- Proximate (Protein, Fat, Fiber, Energy, Total Carbohydrates, Moisture and Ash
- Vitamins ( A, B Complex such as B1, B2,B3,B5,B6,B7,B9,B12, C, D, E, and K
- Macro and Micro Minerals/ Nutrients (Iron, Calcium, Potassium, Magnesium, Sodium, Manganese, Zinc e.t.c
- Heavy Metals (Mercury, Lead, Arsenic, Cadmium, Copper, Boron e.t.c
- Antibiotics tests in Milk, Eggs and Meat
- Amino Acids and Fatty Acids Profiling
iii) We check for micro-organism contamination in food, water, swabs and air. Our scope includes;
- Total Plate/Aerobic/Viable Count
- Total Coliforms Count
- Escherichia Coli
- Staphylococcus Aureus
- Salmonella spp
- Yeast and Molds
- Shigella
- Listeria Monocytogene
- Pseudomonas Aeruginosa
- Streptococcus Faecalis
- Bacilus Cereus among others
Interfield Food Testing Laboratories (IFTL) is a specialised, independent & accredited quality testing and food safety laboratory based in Kiambu County - Kenya.

Kenya | Uganda | Tanzania | Burundi | Rwanda
Book Our ServicesWe've received alot of support from our clients and partners.Here's some of their feedback working with us.

